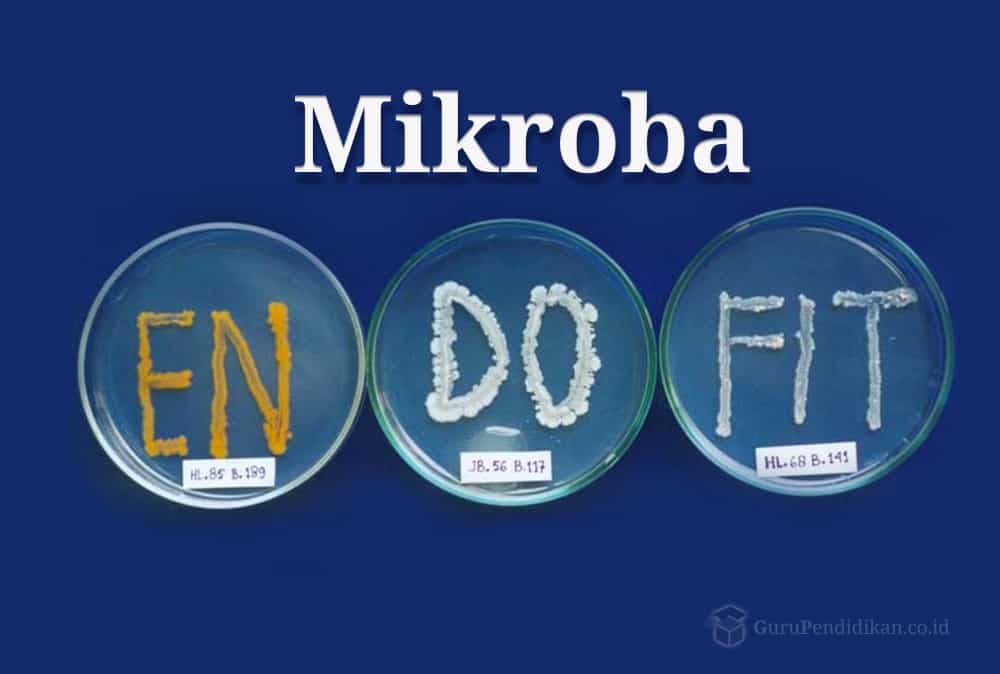

Mikroba Endofit : Pengertian, Jenis, Manfaat, & Sifat adalah mikroba yang hidup di dalam jaringan tanaman pada periode tertentu dan mampu hidup dengan membentuk koloni dalam jaringan tanaman tanpa membahayakan inangnya

Baca Juga Artikel Yang Mungkin Berhubungan : Pedosfer : Pengertian, Ciri, Dan Faktor Terbentuknya Beserta Jenisnya Secara Lengkap
Contents
- 1 Pengertian Mikroba Endofit
- 2 Jenis -Jenis Mikroba Endofit
- 3 Mikroba Endofit Penghasil Antibiotik
- 4 Sifat Mikroba Endofit
- 4.1 1. Metodologi Isolasi mikroba endofit
- 4.2 2. Uji produksi
- 4.3 3. Seleksi jamur endofit penghasil antimikrobia (antibiotik)
- 4.4 4. Identifikasi pendahuluan senyawa antimikrobia
- 4.5 5. Hasil Dan Pembahasan Isolasi jamur endofit dari beberapa spesies tanaman
- 4.6 6. Seleksi berdasarkan cara bioassay produksi metabolit sekunder
- 5 Manfaat Mikroba endofit
- 6 Fungsi dan Tujuan Mikroba Endofit
- 7 website Pelajaran SD SMP SMA dan Kuliah Terlengkap
Pengertian Mikroba Endofit
Mikroba endofit adalah mikroba yang hidup di dalam jaringan tanaman pada periode tertentu dan mampu hidup dengan membentuk koloni dalam jaringan tanaman tanpa membahayakan inangnya.Berbeda dengan mikroba epifit yang hidup pada permukaan jaringan tumbuhan. Oleh karena itu, bakteri endofit dapat diisolasi dari permukaan jaringan tanaman atau diekstrak dari jaringan internal tumbuhan. Endofit masuk ke jaringan tanaman pertama kali melalui akar. Tempat masuknya udara dari bagian tanaman seperti bunga, daun, dan kotiledon dapat juga digunakan sebagai tempat masuknya endofit ke dalam jaringan tanaman. Bakteri masuk ke jaringan tumbuhan melalui akar kecambah, kedua akar, stomata, atau melalui kerusakan bagian tanaman. Interaksi bakteri endofit dengan tanaman dapat menghasilkan senyawa-senyawa bioaktif diantaranya senyawa antibakteri, antifungi, dan antiserangga yang berperan sebagai agen hayati. Selain itu, bakteri endofit juga berperan meningkatkan ketersediaan beberapa nutrisi dan menghasilkan hormon pertumbuhan seperti etilen, auksin, dan sitokinin.
Bakteri endofit dapat dijadikan sebagai agen pemacu pertumbuhan, bakteri endofit berasosiasi dengan jaringan internal tanaman dengan mengadakan suatu rangsangan pertumbuhan yang relatif sama seperti PGPR (Plant GrowthPromoting Rhizobacteria). Beberapa bakteri endofit mempunyai pengaruh yang menguntungkan bagi tanaman inang, seperti memacu pertumbuhan tanaman, meningkatkan resistensi tanaman dari patogen, dan meningkatkan fiksasi N bagi tanaman. Bakteri endofit awalnya berasal dari lingkungan eksternal dan masuk ke dalam tanaman melalui stomata, lentisel, luka (seperti adanya trichomes yang rusak), melalui akar lateral dan akar yang berkecambah. Bakteri Endofit yang mampu memfiksasi nitrogen disebut dengan bakteri endofit diazotrof. Fiksasi nitrogen dari atmosfer akan diubah ke dalam bentuk yang lebih mudah digunakan seperti amoniak. Setiap spesies dapat memfiksasi nitrogen dan kemungkinan ada juga strain yang tidak dapat memfiksasi nitrogen. Endofit juga dapat memberikan keuntungan lain pada tanaman. Pertumbuhan tanaman dapat dipercepat oleh semua kelompok endofit, juga memudahkan dalam penyerapan nutrisi, atau mensintesis hormon tanaman.
Setiap tanaman tingkat tinggi dapat mengandung beberapa mikroba endofit yang mampu menghasilkan senyawa biologi atau metabolit sekunder yang diduga sebagai akibat koevolusi atau transfer genetik (genetic recombination) dari tanaman inangnya ke dalam mikroba endofit. Kemampuan mikroba endofit memproduksi senyawa metabolit sekunder sesuai dengan tanaman inangnya merupakan peluang yang sangat besar dan dapat diandalkan untuk memproduksi metabolit sekunder dari mikroba endofit yang diisolasi dari tanaman inangnya tersebut.
Sekitar 300.000 jenis tanaman yang tersebar di muka bumi ini, masing-masing tanaman mengandung satu atau lebih mikroba endofit yang terdiri dari bakteri dan jamur. Sehingga apabila endofit yang diisolasi dari suatu tanaman obat dapat menghasilkan alkaloid atau metabolit sekunder sama dengan tanaman aslinya atau bahkan dalam jumlah yang lebih tinggi, maka tidak perlu menebang tanaman aslinya untuk diambil sebagai simplisia, yang kemungkinan besar memerlukan puluhan tahun untuk dapat dipanen.
Baca Juga Artikel Yang Mungkin Berhubungan : Pengertian Senyawa Polifenol pada Tanaman
Jenis -Jenis Mikroba Endofit
Berbagai jenis endofit telah berhasil diisolasi dari tanaman inangnya, dan telah berhasil dibiakkan dalam media perbenihan yang sesuai. Demikian pula metabolit sekunder yang diproduksi oleh mikroba endofit tersebut telah berhasil diisolasi dan dimurnikan serta telah dielusidasi struktur molekulnya. Beberapa diantaranya adalah :
- Mikroba endofit yang menghasilkan antibiotika Cryptocandin
adalah antifungi yang dihasilkan oleh mikroba endofit Cryptosporiopsis quercina yang berhasil diisolasi dari tanaman obat Tripterigeum wilfordii, dan berhasiat sebagai antijamur yang patogen terhadap manusia yaitu Candida albicans dan Trichopyton spp. Beberapa zat aktif lain yang diisolasi dari mikroba endofit misalnya ecomycin diproduksi oleh Pseudomonas viridiflava juga aktif terhadap Cryptococcus neoformans dan C.albicans. Ecomycin merupakan lipopeptida yang disamping terdiri dari molekul asam amino yang umum juga mengandung homoserin dan beta-hidroksi asam arpartat, sedangkan senyawa kimia yang diproduksi oleh mikroba endofit Pseudomonas Syringae yang berhasiat sebagai anti jamur adalah pseudomycin, yang dapat menghambat pertumbuhan Candida albicans dan Cryptococcus neoformans. Pestalotiopsis micrispora, merupakan mikroba endofit yang paling sering ditemukan di tanaman hutan lindung di seluruh dunia. Endofit ini menghasilkan metabolit sekunder ambuic acid yang berhasiat sebagai antifungi.
Phomopsichalasin, merupakan metabolit yang diisolasi dari mikroba endofit Phomopsis spp. berhasiat sebagai anti bakteri Bacillus subtilis, Salmonella enterica, Staphylococcos aureus, dan juga dapat menghambat pertumbuhan jamur Candida tropicalis. Antibiotika berspektrum luas yang disebut munumbicin, dihasilkan oleh endofit Streptomyces spp.strain NRRL 30562 yang merupakan endofit yang diisolasi dari tanaman Kennedia nigriscans, dapat menghambat pertumbuhan Bacillus anthracis, dan Mycobacterium tuberculosis yang multiresisten terhadap berbagai obat anti TBC. Jenis endofit lainnya yang juga menghasilkan antibiotika berspaktrum luas adalah mikroba endofit yang diisolasi dari tanaman Grevillea pteridifolia. Endofit ini menghasilkan metabolit kakadumycin. Aktifitas antibakterinya sama seperti munumbicin D, dan kakadumycin ini juga berkhasiat sebagai anti malaria.
- Mikroba endofit yang memproduksi antivirus Jamur endofit Cytonaema sp.
Dapat menghasilkan metabolit cytonic acid A dan B, yang struktur malekulnya merupakan isomer p-tridepside, berhasiat sebagai anti virus. Cytonic acid A dan B ini merupakan protease inhibitor dan dapat menghambat pertumbuhan cytomegalovirus manusia.
- Mikroba endofit yang menghasilkan metabolit
sebagai antikanker Paclitaxel dan derivatnya merupakan zat yang berkhasiat sebagai antikanker yang pertama kali ditemukan yang diproduksi oleh mikroba endofit. Paclitaxel merupakan senyawa diterpenoid yang didapatkan dalam tanaman Taxus. Senyawa yang dapat mempengaruhi molekul tubulin dalam proses pembelahan sel-sel kanker ini, umumnya diproduksi oleh endofit Pestalotiopsis microspora, yang diisolasi dari tanaman Taxus andreanae, T. brevifolia, dan T. wallichiana. Saat ini beberapa jenis endofit lainnya telah dapat diisolasi dari berbagai jenis Taxus dan didapatkan berbagai senyawa yang berhasiat sebagai anti tumor. Demikian pula upaya untuk sintesisnya telah berhasil dilakukan.
- Mikroba endofit penghasil zat anti malaria Colletotrichum sp.
Merupakan endofit yang diisolasi dari tanaman Artemisia annua, menghasilkan metabolit artemisinin yang sangat potensial sebagai anti malaria. Disamping itu beberapa mikroba endofit yang diisolasi dari tanaman Cinchona spp, juga mampu menghasilkan alkaloid cinchona yang dapat dikembangkan sebagai sumber bahan baku obat anti malaria (Simanjuntak P., et.al. 2002).
- Endofit yang memproduksi antioksidan Pestacin dan isopestcin
merupakan metabolit sekunder yang dihasilkan oleh endofit P. microspora. Endofit ini berhasil diisolasi dari tanaman Terminalia morobensis. Baik pestacin ataupun isopestacin berhasiat sebagai antioksidan, dimana aktivitas ini diduga karena struktur molekulnya mirip dengan flavonoid.
- Endofit yang menghasilkan metabolit yang berkhasiat sebagai antidiabetes.
Endofit Pseudomassaria sp menghasilkan metabolit sekunder yang bekerja seperti insulin. Dalam uji praklinik terhadap binatang coba membuktikan bahwa aktivitasnya sangat baik dalam menurunkan glukosa darah tikus yang diabetes. Hasil tersebut diperkirakan dapat menjadi awal dari era terapi baru untuk mengatasi diabetes dimasa mendatang (Zhang B. et.al.1999).
- Endofit yang memproduksi senyawa imunosupresif obat-obat imunospresif
merupakan obat yang digunakan untuk pasien yang akan dilakukan tindakan transplantasi organ. Selain itu imunosupresif juga dapat digunakan untuk mengatasi penyakit autoimum seperti rematoid artritis dan insulin dependentdiabetes. Senyawa subglutinol A dan B yang dihasilkan oleh endofit Fusarium subglutinans yang diisolasi dari tanaman T. wilfordii, merupakan senyawa imunosupresif yang sangat poten (Lee,J., et.al. 1995).
Baca Juga Artikel Yang Mungkin Berhubungan : Pengertian Biogum dan Gum Xanthan Ilmu Biologi
Mikroba Endofit Penghasil Antibiotik
Seleksi dan produksi senyawa antibiotik baru penghambat/pembunuh mikrobia eukariot patogen. Selain sulitnya menemukan antibiotik baru juga sulit memproduksinya. Beberapa medium dan kondisi optimal yang cocok perlu dicoba untuk penghasilan antibiotik. Beberapa faktor substrat (prekusor) berpengaruh terhadap mekanisme biosintesis antibiotik yang bersangkutan, misalnya sumber carbon (C), nitrogen (N) dan beberapa vitamin.
Penggunaan antibiotik dunia lebih dari 40.000 ton/ tahun dalam industri pangan, pakan, pertanian, kesehatan, biokimia, genetika, dan biologi molekuler serta ada kecenderungan meningkat. Ragam antibiotik cukup banyak namun sifat intrisiknya dapat menimbulkan resistensi terhadap mikrobia target sehingga senyawa ini tidak lagi dapat diaplikasikan. Oleh karena itu, langkah-langkah mendapatkan jenis antibiotik baru masih sangat diperlukan baik lewat sintesis kimia, biokimia baru atau penemuan isolat mikrobia baru.
Dalam dua dekade ini, jasad endofit merupakan salah satu sumber utama mikrobia penghasil antibiotik baru, salah satunya adalah jenis jamur. Brunner dan Petrini (1992) melakukan sekrining terhadap lebih dari 80 spora jamur, didapatkan bahwa 79% jamur yang mampu menghasilkan antibiotik adalah kelompok endofit. Selain itu, Tscherter dan Dreyfuss (1992) meneliti beberapa jamur endofit dan mendapatkan Cryptosporiosis spp. mampu menghasilkan metabolit sekunder dengan spectrum patogenisitas lebar, dan beberapa peneliti lain memulai memanfaatkan mikrobia endofit sebagai sumber antibiotik baru.
Hasil penelitian pendahuluan diperoleh isolat mikrobia dari kelompok jamur, bakteri, maupun khamir. Isolasi mikrobia dari beberapa jaringan tumbuhan yang hampir punah di pulau Jawa, memperoleh 61 isolat jamur. Pada penelitian ini isolat-isolat tersebut diseleksi kemampuannya menghasilkan antibiotik (metabolit sekunder) dengan indicator mikrobia Bacillus subtilis (prokariot), Candida albicans dan Fusarium sp. (eukariot). Fusarium sp. Jamur patogen penyerang tanaman pisang panili, tebu, jagung, sorghum dan lain-lain; Candida albicans merupakan patogen pada manusia; dan Bacillus subtilis mewakili bakteri Gram positif patogen.
Baca Juga Artikel Yang Mungkin Berhubungan : Pengertian Ekologi dan Menurut Para Ahli
Sifat Mikroba Endofit
1. Metodologi Isolasi mikroba endofit
Ranting tanaman dipotong sepanjang 1 cm. Untuk mensterilkan permukaan, potongan ranting direndam di dalam larutan Byclean atau Chlorox 5 % selama 5 menit, diikuti dengan perendaman dalam air steril selama 2 menit, entanol 70% selama 1 menit, dan air steril selama 2 menit. Potongan yang telah disterilkan dihilangkan ekses airnya dan selanjutnya dibelah menbujur menjadi 2 bagian. Inokulasi dilakukan dengan cara meletakkan permukaan belahan pada permukaan medium CMM (corn meal malt extract) agar untuk isolasi fungi atau Nutrien agar untuk isolasi bakteri. Inkubasi dilakukan selama 4-7 hari. Koloni mikrobia diisolasi dengan ose, selanjutnya isolat fungi dipelihara pada medium PDA miring dan isolat bakteri dipelihara pada Nutrien agar miring sebagai kultur stok murni.
2. Uji produksi
Dilakukan memakai medium Antibiotik-3 dan PGY, Nutrien, dan PD cair selama 4 -5 hari, inkubasi pada temperatur kamar, digojog 125 ketukan atau 150 rpm. Sel dipisahkan dengan sentrifugasi pada kecepatan 6000 rpm selama 15 menit. Supernatan dipisahkan dan disimpan pada temperatur dingin, dan selanjutnya dipakai untuk pengujian antimikrobia.
• Komposisi medium Antibiotik-3 (g/l: Beef extract 1,5, yeast extract 1,5, peptone 5,0, NaCl 3,5, dekstrosa 1,0, dipotassiumphosphate 3,65, dan monopotassiumphosphate 1,32 (Formula Difco Laboratory, USA) .
• Medium GY(Glyserol and Yeast extract) (g/l : gliserol 5, glukosa 3, polipepton 2, yeast extract 3, NaCl, dan CaCO3 ditambahkan sesudah pH diatur menjadi 6,0. Nutrien (Oxoid)
• PD (potato dextrose).
3. Seleksi jamur endofit penghasil antimikrobia (antibiotik)
Langkah pertama seleksi dilakukan dengan teknik “paper discdiffusion technique”, yakni dengan jalan mencelupkan paper disc ke dalam supernatant dan hindarkan ekses air. Paper disc yang sudah bebas ekses air diletakan pada medium yang mengandung mikrobia indikator Bacillus subtilis, Candida albicans, dan Fusariumoxysporum f.sp. licopersicae dan diinkubasi pada suhu kamar, selama 2 hari. Terbentuknya zone jernih di sekitar paper disc menggambarkan adanya aktivitas penghambatan oleh senyawa antimikrobia (antibiotik) terhadap mikroba indikator. Seleksi isolat dilakukan dengan mengkompilasi hasil uji ini. Isolat yang memiliki nilai rasio lebih besar 4 menjadi kandidat isolat unggul.
4. Identifikasi pendahuluan senyawa antimikrobia
Penetapan senyawa antimikrobia pada supernatant dilakukan teknik kromatografi kertas. Spotting supernatan pada kertas kromatografi sebanyak 20.mL dengan menggunakan micro syringe. Spot dikembang-kan dengan berbagai eluen yaitu eluen A (Ammoniumchloride 20 % dalam akuades), B (akuades yang dijenuhi butanol), C (butanol : asam asetat: air = 3:1:1), D (aseton : butanol : air (5 : 4 : 1) dan E (akuades yang dijenuhi asam asetat). Bercak kromatogram yang dihasilkan selanjutnya diidentifikasi dengan teknik “bioassay” dan menggunakan mikroba indikator.
5. Hasil Dan Pembahasan Isolasi jamur endofit dari beberapa spesies tanaman
Sampel tanaman diambil dari berbagai macam tanaman (25 spesies tanaman)
No Nama Tanaman Nama Ilmiah/ latin Kode Isolat Jmlh Fungi
1 Srikoyo/Kemulwo Annona squamosa KMW 4
2 Mimba Azadirachta indica MB 5
3 Kemuning Aglais odorata KMN 8
4 Mahkota dewa Phaleria macrocarpa MD 4
5 Kemiri Aleurites moluccana KMR 3
6 Sawobludru Diospiros rabola SB 5
7 Pelem Mangifera indica PLM 3
8 Kepel Stelechocarpus bulahol KPL _
9 Kakao Theobroma cacao KKO 5
10 Jambu air Syzygium aqueum/ S. javanica JA 2
11 Belimbing Averhoa carambola BLB 3
12 Kelengkeng Euphoria longana KLK 3
13 Preh/ Beringin Ficus benyamina PREH 1
14 Kayu putih Eucalypthus alba/smithii KYP 4
15 Nangka Artocarpus heterophyllus NGK 6
16 Kitiran Corypha utan KTR 4
17 Kelengkeng Caesalpinea crista KLK 3
18 Sirih Piper Piper betle SRH 3
19 Alpokat Persea gratissima/ americana APK 3
20 Salam Syzygium polyanthum SLM 3
21 Melati Jasminum sambas MLT 4
22 Sawo kecik Manikara kauki SK 3
23 Kenanga Cananga odorata KNG _
24 Jambu kluthuk Psidium guajava JKL _
25 Benalu(Kemladean) Loranthus parasiticus KMD 7
Total isolat fungi 86
Tabel I. Tanaman sumber dan jumlah isolat jamur endofit
Isolasi dilakukan menggunakan CMM (corn meal malt medium), yang dimodifikasi dengan penambahan pepton dan ekstrak khamir. Isolat yang tumbuh di sekitar ranting diisoslasi dan dikulltivasi pada medium PDA, serta disimpan dalam lemari pendingin.
Hasil isolasi jamur endofit (Tabel I). Isolasi dari tanaman Kepel, Arumdalu dan Jambu Kluthuk tidak diperoleh isolat, diduga karena sampel diambil dari bagian pucuk tanam/ ranting dan populasinya sangat sedikit. Sampel dari tanaman atau organ tanaman tua misalnya Benalu, Nangka, Belimbing, Kayu putih, Srikoyo, Pelem dan Kemuning dapat diisolasi banyak isolat, asumsinya pada belahan ranting sepanjang 1 cm dipenuhi oleh populasi mikroba sedangkan organ atau tanaman muda memiliki kondisi yang sebaliknya. Delapan puluh enam (86) isolat berhasil diisolasi dan selanjutnya diuji kemampuannya memproduksi metabolit sekunder/antibiotik yang mampu menghambat/membunuh mikroba, Bacillus subtilis. Candida albicans dan Fusariumoxysporum f. sp. licopersicae.
Produksi antibiotik dilakukan pada berbagai medium yang memberikan gambaran sumber karbon atau substrat spesifik sebagai pemicu/pemacu dalam metabolism substrat menjadi agensia antibiotik, diantaranya adalah PDB (potato dextrose broth), Antibiotik-3 dan GY (Glyserol and Yeast extract).
Petrini et al., (1992) melakukan skrining terhadap lebih dari 80 spora endofit dan menghasilkan 79 % spora fungi yang mampu menghasilkan antibiotik, selain itu Dreyffus (1992) dalam Petrini et al., (1992) berhasil mendapatkan fungi Cryptosporiopsis yang mampu menghasilkan antibiotik berspektrum lebar. Huang dan Kaneko (1996) melaporkan bahwa lebih dari 400 metabolit sekunder dihasilkan oleh kelompok fungi Pyrenomycetes dan Loculoascomycetes, dimana fungi endofit merupakan anggota kelompok fungi ini yang juga mampu menghasilkan antibiotik penghambat fungi dan bakteri. Martani, et al., (2002) berhasil mengisolasi 48 isolat jamur dari 19 tanaman dan 19 isolat diantaranya mampu memproduksi antibiotik, 39,5 %. Margino, et al., (2001) berhasil mengisolasi sebanyak 34 isolat penghasil antibiotik dari 44 isolat jamur endofit, 77, 3 %.
6. Seleksi berdasarkan cara bioassay produksi metabolit sekunder
| Medium | B. subtilis | C. albicans | F. oxysporum |
| PDB | 11 | 1 | 1 |
| Antibiotik-3 | 24 | 3 | 24 |
| GY | 12 | 16 | 17 |
Tabel II. Jumlah isolat penghasil antibiotik dalam medium PDB, Antibiotik-3 dan GY dan indicator Bacillus subtilis, Candida albicans, dan Fusarium oxyaporum f.sp. licopersicae
| NO | Medium | Kode Isolat | Produksi metabolit sekunder pada berbagai Medium dan daya hambatnya > 2,0 | |||
| B. subtilis | C. albicans | F. oxysporum | ||||
| 1 | PDB | JA-2 | 5,5 | _ | _ | |
| 2 | APK-1 | 5,2 | _ | _ | ||
| KMD-7 | _ | 7 | 3,5 | |||
| 3 | Antibiotik-3 | ANTIBIOTIK-3 MB- 1 | _ | _ | 5,6 | |
| 4 | SB-3 | 5,2 | _ | _ | ||
| 5 | KMN-3 | 4,2 | _ | _ | ||
| 6 | JA-1 | 2,5 | _ | 4.2 | ||
| 7 | NGK-1 | 5,2 | _ | 2,3 | ||
| 8 | MLT-2 | 4,5 | _ | _ | ||
| 9 | KMD- 7 | 4,1 | 3,5 | _ | ||
| 10 | GY | GY SB- 4 | 3,5 | _ | _ | |
| 11 | KYP-2 | 4,1 | _ | _ | ||
| 12 | SRH-3 | 3,4 | _ | 2,7 | ||
| 13 | 13 APK-2 | _ | _ | 2,5 | ||
Tabel III. Produksi metabolit sekunder fungi endofit pada medium cair PDB, ANTIBIOTIK-3, dan GY, dan uji bioassainya dengan mikroba indikator Bacillus subtilis. Candida albicans dan Fusarium oxysporum f.sp.licopersicae
Potato Dextrose Broth (PDB) kurang dapat memicu produksi antibiotik baik yang mampu menghambat mikroba prokariot gram positif (B. subtilis) maupun eukariot (C. albicans dan Fusariumoxyaporum f.sp. licopersicae). Walaupun belum maksimal ketiga macam medium tersebut dapat dipakai untuk menjaring produksi antibiotik oleh isolat-isolat jamur endofit, dari 86 isolat khususnya medium Antibiotik-3 merupakan substrat terbaik untuk memproduksi antibiotik penghambat B. subtilis demikian halnya dengan daya hambat yang dihasilkan di atas rata-rata daya hambatnya bila dibandingkan dengan PDB dan GY Tabel II. Namun demikian medium GY memberikan hasil terbanyak walau bukan terbaik untuk memproduksi antibiotik penghambat C. albicans dengan jumlah 16 isolat dan F. oxysporum sebanyak 17 isolat
Hitungan prosentase penjaringan isolat jamur endofit menggunakan medium GY sebanyak 45/86..x..100.% = 52,33.%, medium Antibiotik-3 sebanyak 42/86 x 100 % = 48,84 %, dan medium PDB sebanyak 13/86x 100 % = 15,16 %, (Tabel II).
Isolat-isolat unggul hasil seleksi atas dasar daya hambat antibiotik terhadap berbagai mikrobia indikator disajikan pada Tabel III, tabel ini memberikan gambaran yang lebih mantap kaitannya rencana aplikasi produksi antibiotik di kemudian hari sesuai dengan pengembangan jenis jamur dan kualitas dan kuantitas produksi antibiotiknya. Oleh karena itu, karakterisasi atau identifikasi pendahuluan senyawa antibiotik dilakukan terhadap beberapa isolat yang memiliki potensi pengembangan di kemudian hari.
Bioassay sampai tahap penetapan seleksi menggunakan indikator B.subtilis, C.albicans, dan F.oxysporum. Hasil penelitian menunjukkan bahwa sangat sedikit isolat yang mampu menghambat C. albicans, dengan diameter 7-10 mm sedangkan paper disc yang dipakai berdiameter 6 mm. Hasil penghambatan terhadap B. subtilis yang memiliki diameter penghambatan lebih dari 2 sebanyak 15 isolat dan 9 isolat memiliki diameter penghambatan sama dengan atau lebih dari 40 mm, Tabel III. Tiga isolat unggul dalam aplikasinya di bidang pertanian maupun kesehatan manusia, JA-2 memiliki nisbah daya hambat sebesar 5,5 terhadap Bacillus subtilis, MB-1 memiliki daya hambat sebesar 5,6 terhadap Fusariumoxysporum, dan KMD-7 memiliki daya hambat 4,1 terhadap B. subtilis dan daya hambat 3,5 terhadap C. albicans. Yulianah, dkk. (1987) melaporkan bahwa medium yang mengandung glukosa 1,0% dan yeast extract 0,25..% dapat dipakai oleh Streptomyces indonesiensis ATCC 35859 untuk meningkatkan produksi antibiotik (antifungi) berspektrum luas. Cheeptam (1999) melaporkan bahwa medium yang mengandung gliserol dapat meningkatkan produksi antibiotik (anti fungi/bakteri), dan dalam penelitiannya produksi antibiotik mencapai maksimal menggunakan Ellishiodothis inquinans L1588-A8 dalam medium yang mengandung gliserol 5,0.% dan yeast extract 0,4.%.
Antibiotik banyak dihasilkan oleh isolat yang ditumbuhkan pada medium yang mengandung F-4 dan GY, selain mengadung senyawa kompleks (tepung kedelai pada medium F-4), juga banyak mengandung gliserol. Dalam proses metabolisme mikroba pada umumnya gliserol dan glukosa diubah menjadi asam piruvat lewat pathway glikolisa dan acetil-KoA yang dibutuhkan dalam siklus asam trikarboksilat (TCA cycle) untuk proses respirasi. Glukosa dan gliserol merupakan substrat penting dalam pertumbuhan dan biosintesis penghasilan metabolit sekunder, termasuk antibiotik (Cheeptam, 1999). Peneliti lain, Margino, et al., (2001) menunjukkan bahwa banyak antifungi diproduksi pada medium F-4 dan GY dibandingkan PDY, yakni hampir 40% medium F-4 dab GY mampu memacu produksi antifungi yang menghambat Alternaria sp. Hasil karakterisasi senyawa antibiotik dengan teknik kromatografi dilakukan dengan berbagai eluenseperti Ammonium Klorida 20% ; Air dijenuhi Butanol ; Butanol: Asam asetat : Air (3:1:1) ; Aseton:Butanol:Air (5:4:1) ; Air dijenuhi Asam asetat ; Sampel ditotolkan sebanyak 20 ML.
Teknik kromatografi ini berbasis pada tingkat polaritas senyawa antibiotik dan berapa macam senyawa yang dikandung dalam larutan ektraseluler jamur endofit sesudah ditumbuhkan di berbagai medium. Perbedaan nilai Rf sebagai kunci macam dan jumlah senyawa antibiotik yang bersangkutan. Salah satu sifat fisik antibiotik terhadap pengaruh eluen adalah angka polaritasnya, sehingga polaritas pelarut atau eluen menentukan jarak pergerakan ‘bercak’ dari tempat totolan mencapai jarak tertentu, nilai ini selanjutnya dikenal sebagai retardation force (Rf) sesudah dibandingkan dengan jarak dimana titik elusi diakhiri.
Tabel IV. Nilai Rf antibiotik yang dielusi dengan eluen B,C,D, dan E, Mikroba indikator B. subtilis, C. albicans,dan F. oxysporum f.sp. licopersicae
| No | Isolat | Mikroba Indikator | Nilai RF dari eluen | ||||
| A | B | C | D | E | |||
| 1 | NGK-1 | B. Subtilis | _ | _ | 0,75 | _ | 0,80 |
| 2 | SB-3 | B. Subtilis | _ | _ | 0.3 | _ | _ |
| 3 | JA-2 | B. Subtilis | _ | _ | 0,91 | _ | _ |
| 4 | KMN-3 | B. Subtilis | _ | 0,21 ; 0,94 | _ | _ | _ |
| 5 | MLT-2 | B. Subtilis | _ | 0,85 | _ | _ | _ |
| 6 | APK-1 | B. Subtilis | _ | 0,34 ; 0,93 | _ | _ | _ |
| 7 | KYP-2 | B. Subtilis | _ | 0,74 | _ | 0,30 | _ |
| 8 | KMD-7 | C. albicans | _ | _ | _ | _ | _ |
| KMD-7 | B. Subtilis | _ | 0,48 | 0,78 | _ | _ | |
| 9 | MB-1 | F. oxysporum | _ | _ | _ | _ | _ |
Ket : A : Ammonium Klorida 20% ; B: Air dijenuhi Butanol ; C: Butanol: Asam asetat : Air (3:1:1) D: Aseton:Butanol:Air (5:4:1) ; E: Air dijenuhi Asam asetat ; Sampel ditotolkan sebanyak 20 ML
Antibiotik yang dihasilkan oleh NGK-1 memiliki nilai Rf : 0,75 setelah dielusi dengan Butanol:Asetat :Air (3 :1 :1) dan nilai Rf :0,80 pada eluen Air dijenuhi Asetat, dengan perkataan lain bahwa untuk pemanenan antibiotik tersebut dapat mempergunakan campuran pelarut tersebut setelah proses produksi secara fermentasi.Demikian halnya dengan isolat SB-3 dan JA-2 berturut memiliki nilai Rf : 0,30 dan 0,91 pada eluen Butanol:Asetat :Air (3 :1 :1). Isolat KMD- 7 mampu memproduksi antibiotik penghambat C. albicans namun nilai Rf nya belum diketahui menggunakan kelima jenis eluen tersebut sehingga tidak muncul pada percobaan ini.
Isolat APK-1 memproduksi 2 macam antibiotik yang menghambat B. subtilis dan memiliki nilai Rf berturut-turut 0,34 dan 0,93 bila dielusi dengan eluen air yang dijenuhi butanol, demikian halnya isolat KMN-3 memiliki 2 macam antibiotik dengan nilai Rf 0,21 dan 0,94 apabila sampel dielusi dengan air yang dijenuhi butanol. Antibiotik yang diproduksi oleh isolatKMN-3, MLT-2, APK-1, KYP-2, dan KMD-7 dan menghambat B. subtilis memiliki polaritas sejenis walau secara rinci nilai Rf mereka mayoritas berbeda tetapi antibiotik KMN-3 dan APK-1 ada yang mirip karena nilai Rf mereka 0,93 dan 0,94, dimungkinkan antibiotik ini jenis dan bahan aktifnya sama. Beberapa antibiotik seperti penisilin, rosamisin, dan sefalosporin C, N dan P dapat diidentifikasi dengan menggunakan pelarut butanol: asam acetat: air (3:1:1). Sebagai pembanding diketahui bahwa rosamisin memiliki nilai Rf : 0,31; 0,37 dan 0,44 , sedangkan sefalosporin N dengan perbandingan pelarut (eluen) butanol : asam acetat : air (12:3:5) memiliki nilai Rf: 0,38.
Perbandingan hasil uji bioassai isolat MB-1 memiliki daya hambat terhadap F. oxysporum dan KMD-7 memiliki daya hambat terhadap C. albicans namun setelah dielusi menggunakan kelima eluen masih belum ditemukan ‘spot ‘ yang memberikan penghambatan terhadap mikroba indikator tersebut. Oleh karena itu, optimasi produksi hanya dapat dilakukan terhadap isolat JA-2 dan NGK-1, dimana JA-2 memiliki daya hambat 5,5 terhadap B. subtilis bila ditumbuhkan pada medium PDB dan NGK-1 memiliki daya hambat 5,2 terhadap B.subtilis dan 2,3 terhadap F.oxysporum bila ditumbuhkan pada medium Antibiotik-3, namun demikian daya hambat NGK-1 tidak sebesar MB-1 terhadap F. oxysporum, yakni 5,6.
Untuk mendapatkan hasil yang optimal, seleksi dilakukan berdasarkan nilai daya hambat antibiotik terhadap mikroba indikator dan rencana aplikasinya di sector pertanian dan kesehatan. Sektor pertanian diwakili oleh Fusariumoxysporum dan sector kesehatan diwakili oleh Bacillus subtilis dan Candida albicans, oleh karena itu dari Tabel III dapat dipilih berturut-turut JA-2 dan NGK-1 sebagai isolat unggul yang memiliki prospek bagus dalam aplikasi di lapangan atau skala fabrikasi setelah melewati serangkaian penelitian lanjutan dan sampai ke tahapan pemurnian dan aplikasi.
Tabel V. Kondisi optimum pertumbuhan dan produksi antibiotik NGK-1 dan JA-2
| Isolat | pH | Agitsi (rpm) | Aetasi (mL/mnt) | Substrat (%) | Temperatur °C | Karbon (Gliserol, g/L) |
| NGK-1 | 6,5 | 125 rpm | 2500 | 5 | 30 | 5 |
| JA-2 | 6,0 | 150 rpm | 3000 | 5 | 30 | 7,5 |

Baca Juga Artikel Yang Mungkin Berhubungan : Keanekaragaman Hayati, Manfaat, Jenis dan Klasifikasi
Manfaat Mikroba endofit
Antibiotika berspektrum luas yang disebut dengan munumbicin tersebut, dihasilkan oleh endofit Streptomyces sp. strain NRRL 30562 yang merupakan suatu endofit yang diisolasi dari tanaman Kennedia nigriscan, yang dapat menghambat pertumbuhan pada Bacillus anthracis, dan juga Mycobacterium tuberculosis yang multiresisten terhadap berbagai jenis obat anti tuberkulosis. Jenis endofit yang lainnya yang dapat menghasilkan antibiotika berspektrum luas ialah mikroba endofit yang diisolasi dari suatu tanaman Grevillia pteridifolia. Endofit tersebut menghasilkan suatu metabolit kakadumycin.
Aktivitas antibakterinya tersebut sama seperti munumbicin, dan juga kakadumycin tersebut juga berkhasiat ialah sebagai anti malaria.
Mikroba endofit yang menghasilkan senyawa antioksidan
Metabolit sekunder yang berkhasiat ialah sebagai antioksidan juga dapat diproduksi dengan mikroba endofit. Pestacin serta isopestacin adalah metabolit sekunder yang dapat dihasilkan dengan endofit Pestalotiopsis microspora. Endofit tersebut dapat berhasil diisolasi dari suatu tanaman Terminalia morobensis, yang tumbuh di daerah Papua New Guinea. Baik pestacin ataupun isopestacin tersebut berkhasiat ialah sebagai antioksidan, yang mana aktivitas tersebut diduga karena adanya struktur molekulnya mirip dengan flavonoid .
Mikroba endofit yang menghasilkan senyawa antikanker
Paclitaxel dan juga derivatnya ialah zat yang berkhasiat ialah sebagai antikanker yang pertama kali ditemukan yang diproduksi oleh mikroba endofit. Paclitaxel adalah senyawa diterpenoid yang didapatkan didalam suatu tanaman Taxus. Senyawa yang dapat mempengaruhi molekul tubulin dalam proses pembelahan sel-sel kanker tersebut, pada umumnya diproduksi oleh endofit Pestalotiopsis microspora, dengan diisolasi dari tanaman Taxus andreanne, T. brevifolia, serta juga T. wallichiana. Saat ini beberapa dari jenis endofit lainnya telah dapat diisolasi dari berbagai jenis Taxus dan juga didapatkan berbagai senyawa yang berkhasiat ialah sebagai anti tumor. Demikian juga upaya untuk sintesisnya telah berhasil dilakukan. Beberapa metabolit sekunder ialah seperti naphtoquinone spiroketal yang dihasilkan oleh jamur endofit Edenia gomespompae, dan juga enam derivat asam tetramik yang juga dihasilkan oleh jamur endofit Penicillium sp. serta Aegiceras corniculatum tersebut , memiliki efek sitotoksik yang tinggi pada sel kanker.
Mikroba endofit yang menghasilkan senyawa antivirus
Jamur endofit Cytonaema sp. tersebut dapat menghasilkan suatu metabolit sekunder cytonic acid A da juga B, yang pada struktur molekulnya adalah isomer p-tridepside, yang berkhasiat ialah sebagai antivirus. Cytonic acid A dan juga B tersebut ialah protease inhibitor dan juga dapat menghambat siati pertumbuhan cytomegalovirus manusia.
Baca Juga Artikel Yang Mungkin Berhubungan : Jaringan Hewan : Jenis, Fungsi, Letak, Gambar Dan Contohnya
Fungsi dan Tujuan Mikroba Endofit
Mikroba endofit yang berfungsi sebagai penghasil isolat anti mikroba. Isolat jamur endofit JA-2 dan NGK-1 mampu memproduksi antibiotik yang dapat menghambat B. subtilis dan F. oxysporum f.sp. licopersicae dan telah diketahui karakter awalnya. Isolat MB-1 memiliki prospek aplikasi di bidang pertanian karena sangat menghambat F. oxysporum f.sp. licopersicae namun belum dapat dikarakterisasi produksi antibiotiknya, sedangkan isolat KMD-7 memiliki potensi tinggi untuk diaplikasikan di bidang kesehatan manusia karena mampu menghambat Candida albicans dan B. Subtilis
Tujuan Mikroba Endofit
- untuk memperoleh mikrobia baru penghasil antibiotik mikrobisidal atau mikrobiostatik baru, sebagai agensia pengendali pathogen manusia dan tanaman.
- Mengetahui aplikasi bidang teknologi yang dapat digunakan dalam pengembangan obat
website Pelajaran SD SMP SMA dan Kuliah Terlengkap
mata pelajaran
jadwal mata pelajaran mata pelajaran sma jurusan ipa mata pelajaran sd mata pelajaran dalam bahasa jepang mata pelajaran kurikulum merdeka mata pelajaran dalam bahasa inggris mata pelajaran sma jurusan ips mata pelajaran sma
bahasa inggris mata pelajaran
bu ani memberikan tes ujian akhir mata pelajaran ipa
tujuan pemberian mata pelajaran pendidikan kewarganegaraan di sekolah adalah
dalam struktur kurikulum mata pelajaran mulok bersifat opsional. artinya mata pelajaran smp mata pelajaran ipa mata pelajaran bahasa indonesia mata pelajaran ips mata pelajaran bahasa inggris mata pelajaran sd kelas 1
data mengenai mata pelajaran favorit dikumpulkan melalui cara
soal semua mata pelajaran sd kelas 1 semester 2 mata pelajaran smk mata pelajaran kelas 1 sd mata pelajaran matematika mata pelajaran ujian sekolah sd 2022
bahasa arab mata pelajaran mata pelajaran jurusan ips mata pelajaran sd kelas 1 2021 mata pelajaran sbdp mata pelajaran kuliah mata pelajaran pkn
bahasa inggrisnya mata pelajaran mata pelajaran sma jurusan ipa kelas 10 mata pelajaran untuk span-ptkin mata pelajaran ppkn mata pelajaran ips sma mata pelajaran tik
nama nama mata pelajaran dalam bahasa inggris mata pelajaran pkn sd mata pelajaran mts mata pelajaran pjok
nama nama mata pelajaran dalam bahasa arab mata pelajaran bahasa inggrisnya mata pelajaran bahasa arab
seorang pengajar mata pelajaran akuntansi di sekolah berprofesi sebagai
nama mata pelajaran dalam bahasa jepang
hubungan bidang studi pendidikan kewarganegaraan dengan mata pelajaran lainnya
dalam struktur kurikulum mata pelajaran mulok bersifat opsional artinya mata pelajaran dalam bahasa arab
tujuan mata pelajaran seni rupa adalah agar siswa